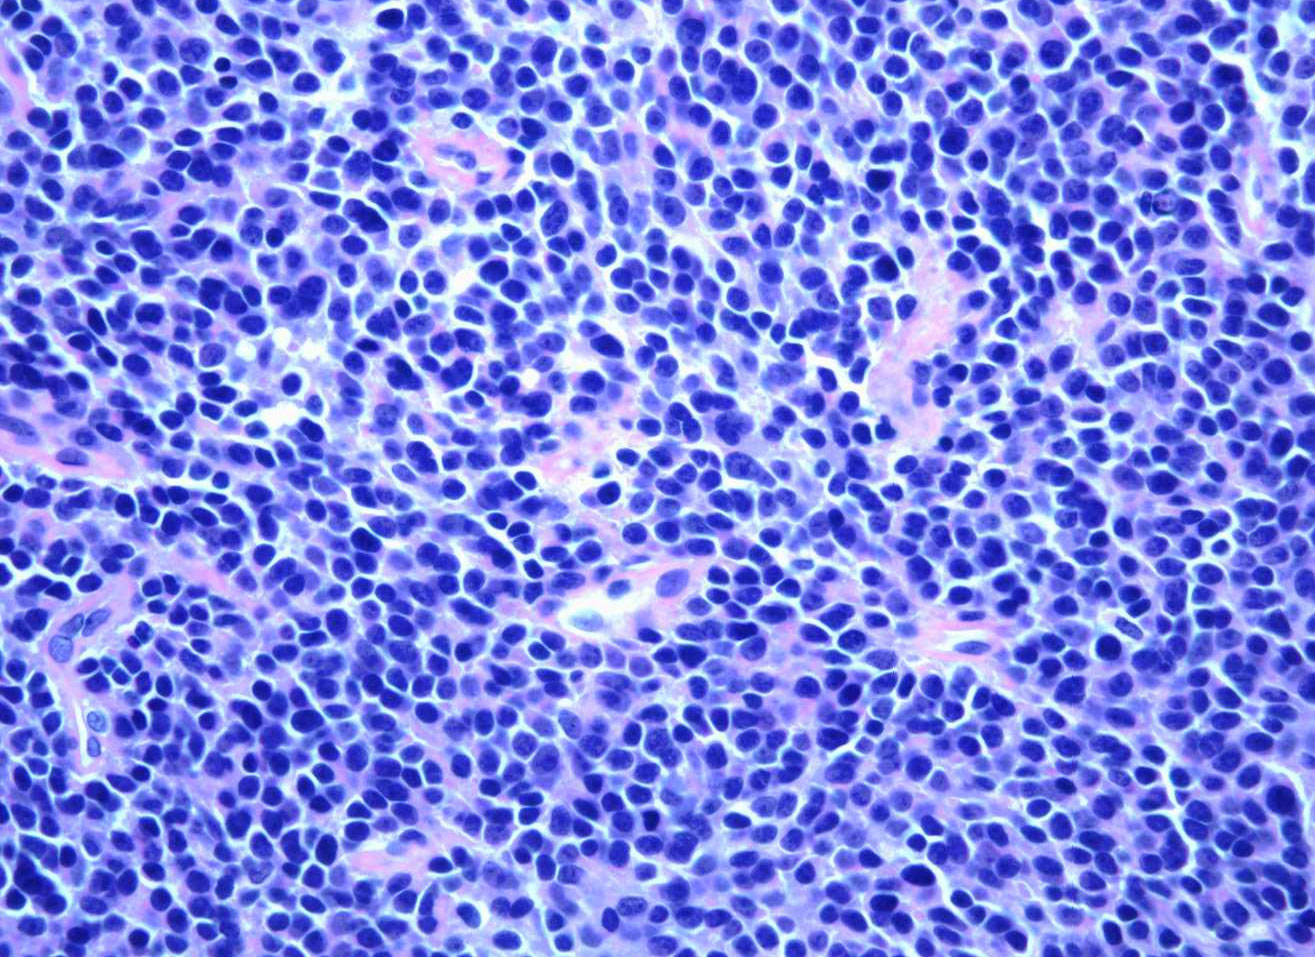

Find information
by body part


POPULAR
About Us
Featured

OrthoInfo Podcast
The OrthoInfo podcast is a monthly series where board-certified orthopaedic surgeons answer frequently asked questions from patients about musculoskeletal issues, treatments, injury prevention, bone health, and more.
article
Explore the Podcast

What is FAAOS?
Searching for a reputable orthopaedic surgeon to treat your musculoskeletal injury, condition, or disease? Start by looking for the letters “FAAOS” (Fellow of the American Academy of Orthopaedic Surgeons) after a doctor’s name.
article
Learn more

OrthoInfo Basics Handouts
These printable PDF handouts address some of the most common musculoskeletal conditions and treatments in plain language designed to maximize reading comprehension. Basics can be customized with a doctor's practice logo and details.
handout
Learn more
Diseases & Conditions
Featured

Shining a Light on Sarcoma
July is Sarcoma Awareness Month, a time to raise visibility for this rare cancer that affects the bone and soft tissue. For the tens of thousands of Americans living with it, the impact is deeply personal and ongoing. Hear stories from survivors and surgeons, and learn how you can support the Musculoskeletal Tumor Registry and help raise awareness about sarcoma.
article
Get Involved
Shoulder Pain and Common Shoulder Problems
Because so many structures make up the shoulder, it is vulnerable to many different problems and injuries — from inflammation to tendon tears to fractures.
article
Read
Patellofemoral Pain Syndrome
Patellofemoral pain syndrome (PFPS) is a broad term used to describe pain in the front of the knee and around the kneecap. It is sometimes called "runner's knee" or "jumper's knee" because it is common in people who participate in sports — especially females and young adults.
article
Read
Sever's Disease
Sever’s disease is one of the most common causes of heel pain in growing children, especially children who are very physically active. It is an inflammation of the growth plate in the calcaneus (heel) that most often occurs during growth spurts, when bones, muscles, tendons, and other structures are changing rapidly.
article
Learn more
Popular
Treatment

Total Knee Replacement
If nonsurgical treatments are no longer managing your arthritis symptoms, you may want to consider total knee replacement. It's a safe, effective procedure to relieve pain, correct leg deformity, and help you resume normal activities.
article
Read the Article

Elbow Arthroscopy
Elbow arthroscopy is used to visualize and treat many problems inside the elbow joint, including tennis elbow and arthritis. It may be recommended if you have a painful condition that does not respond to nonsurgical treatment.
article
Learn More

Finding the Right Orthopaedic Surgeon
These tips can help you find a quality orthopaedic surgeon to treat your musculoskeletal condition, injury, or disease.
article
Learn more
Featured
Total Hip Replacement
Whether you have just begun exploring treatment options or have already decided to undergo total hip replacement surgery, this article will help you understand the benefits and limitations of total hip replacement.

article
Learn more
Platelet-Rich Plasma (PRP)
Over the past few decades, much has been written about platelet-rich plasma (PRP) and its potential effectiveness in the treatment of injuries. But which conditions can PRP help improve?

article
Find out
Popular
Recovery
Popular
Staying Healthy

Exercise and Bone Health
Exercise works on bones much like it works on muscles — it makes them stronger. Exercise is important for building strong bones when we are younger, and it is essential for maintaining bone strength when we are older. It also improves balance and coordination, which becomes especially important as we get older because it helps to prevent falls.
article
Learn more
Calcium, Nutrition, and Bone Health
The health and strength of our bones rely on a balanced diet and a steady stream of nutrients — most importantly, calcium and Vitamin D.
article
Read
Golf Injury Prevention
Most golf injuries are the result of overuse. By repeating the same golf swing motion over and over again, significant stress is placed on the same muscles, tendons, and joints. Over time, this can cause injury.
article
Learn more
Preventing Falls
A fall can be a major life-changing event that robs an elderly person of their independence. Fortunately, many falls can be prevented with healthy lifestyle choices and safety modifications in the home.
article
Learn more